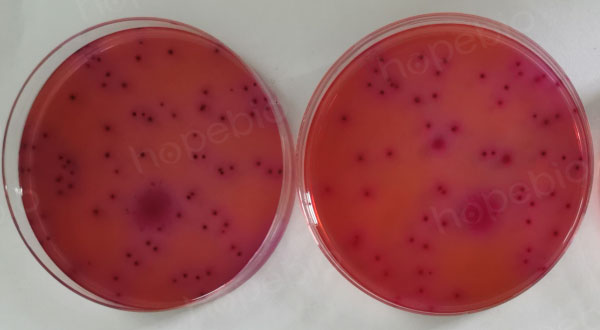
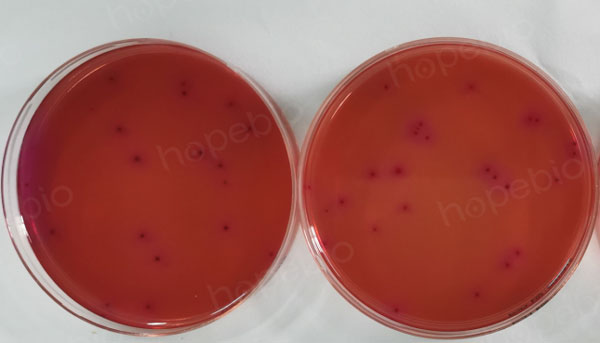

海博微信公众号
海博微信公众号
 海博天猫旗舰店
海博天猫旗舰店


 海博微信公众号
海博微信公众号
 海博天猫旗舰店
海博天猫旗舰店




一、盲样考核简介
盲样考核,是指将未知详细样品信息的待测样品发放给相关检测机构,要求检测员在指定时间内、完成特定样品检测项目并提供相应报告的一种考核形式。盲样考核作为实验室质量控制的重要环节,可直接、客观地反映实验室检测能力,也是实验室水平的重要体现。
对从事检验检测的行业同仁来说,盲样检测是必须掌握的专业技能之一。尤其对于CMA或CNAS认证的实验室,每年更是要面临各类盲样考核,其中能力验证是盲样考核最重要且最主要的来源。
能力验证是对实验室的技术能力的证明,在一个评审周期内若能多次参加能力验证,既可提升实验室的检测、技术能力,同时也是自身技术水平的彰显。本文主要就微生物盲样检测过程中需要注意的事项进行详细阐述。
二、物品准备
1、合理保存、及时检测
与一般样品检测不同的是,微生物盲样的检测,具有很强的时效性。因为盲样中的菌体是活菌体,随着时间的延长,样品中菌体的含量会有所下降,尤其对含定量菌的盲样来说,拿到样品进行第一时间检测尤为重要。如果不能及时检测,或者对检测时间有特殊规定时,要将样品进行合理保存,避免条件不当,造成样品中菌数发生较大变化。
2、周密的准备工作
(1)操作人员:无论是否需要做盲样考核,都要加强日常管理,按照实验操作标准规范来做,熟悉方法原理和操作流程,如果平时严格按照操作规范来做,盲样考核一定没问题。
(2)试剂溶液的准备:需根据检测指标的不同配备对应且充足的试剂溶液,并进行校准以保证实验试剂的准确性。
(3)标准容器:即量具和存放溶液的容器,诸如各个规格的大肚移液管、刻度吸管、容量瓶、锥形瓶等等,都要在进行盲样考核之前清洗干净,必要时可以泡酸处理。同时实验用水、试剂等物质也要提前确定在有效期内且数量充足。
3、仔细阅读作业指导书
对于盲样考核来说,作业指导书就是方向标,会告诉你大量关键信息,尤其对微生物检测来说,仔细研读作业指导书,严格按照要求来做,显得尤为重要。
三、操作要点
1、准确性:所用容器尽量与作业指导书中所述一致。在对冻干菌株盲样进行检测时,虽然大多数步骤都是相似的,但仔细对比,还是有很多不同。比方说容器,样品处理阶段,有的实验室喜欢用锥形瓶,有的喜欢用广口瓶,还有的喜欢用均质袋,并且即使同种容器,规格不同,也会使检验结果差异较大(图1)。
锥形瓶与广口瓶:

均质袋:

图1 试验中常用的稀释容器
2、有关振荡混匀:通常样品的混匀需要用到旋涡振荡器或者拍打式均质器,但有些操作人员也会用手工进行晃动混匀。旋涡振荡20s的效果,如果用手工拍打,需要80多下才能等同,但通常来讲,人工拍打,一般不会拍打那么多次,尤其对于一些无色液体(比如水样)样品,可能会简单摇晃几下就认为已经混匀。而实际上,样品中的菌体并未被均匀分散开,这就造成吸取样品液的时候,吸取的菌数不均匀,并进一步影响后续的稀释过程,直接导致检测结果的误差。所以,在微生物盲样检测过程中,应尽量使用振荡器进行混匀,而非手工摇匀。
3、有关泡沫:样品经过振荡混匀之后,通常上面会产生大量泡沫(图2)。此时,一定不能直接吸取样液进行稀释,而应该静置一段时间,等泡沫消失之后再进行吸取、稀释和计数。如果不这样操作,就会导致大量菌体漂浮在上层泡沫中,造成检测的结果菌数偏低。

图2 旋涡振荡器震荡后样品液体表面的泡沫状态
4、操作:有时候为了试验需要,需要将少量的样品进行转移到较大的容器中,一定要保证所有的样品尽量全部转移。比如说,用1mL稀释液溶化样品后,如果只吸取1mL进行转移,就会漏掉很多菌体。正确的做法应该是多吸几次,保证样品尽量全部转移。
5、培养条件:对于微生物计数的培养基的温度控制,尤为重要。有的作业指导书中明确要求是46℃进行倾注,这个必须是经过恒温水浴锅水浴之后才能确定的,有的人通常只凭经验,用手摸着不烫就进行倾注,这样也会导致结果的差异。对于有些菌种48℃的培养基倾注计出的菌数和46℃倾注培养出的数目是会有很大的差别的。
规范操作检测结果:
不规范操作检测结果:
图3 同一瓶样品规范操作和不规范操作的检验结果差异
综上所述,微生物检测过程的每个环节,都会造成结果不同程度的差异。而这些差异叠加起来,误差就会越来越大,造成最终结果的偏离(图3)。尤其当样品中菌数本身就偏低的情况下,这种误差更会逐级放大,最后甚至造成有菌也检测不出来的情况。所以,提醒每一位参与盲样检测的人员,都应该严格试验操作,格外注意试验过程的细节。
注:本文属海博生物原创,未经允许不得转载。
上一篇:常用菌种的传代与保存方法



